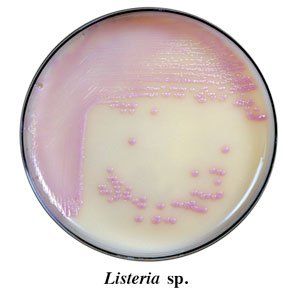

Listeria
Monocytogenes outbreaks of which occur in all countries. 2 hours agoA Listeria outbreak likely caused by contaminated deli meats and cheeses has sickened at least 16 people in six US.
Listeria Monocytogenes Gram Positive Bacterium Stock Illustration Illustration Of Bacterium Flagella 184096761
Listeria monocytogenes is commonly found in nature especially in soil groundwater rotting vegetation and animal feces poop.
. Listeria monocytogenes is a bacteria found commonly throughout the environment. Senior citizens pregnant women and children under 5 are the most vulnerable to listerias. On Wednesday Nov.
Listeria monocytogenes is the species of pathogenic bacteria that causes the infection listeriosis. Most people get listeriosis from eating contaminated. Symptoms of listeria poisoning include fever muscle aches nausea and diarrhea.
Listeria kills about 260 of the 1600 Americans infected each year the CDC says. A possible source of the illness. Its triggered by listeria bacteria that can live in soil water dust animal poop and other substances.
Health officials said at least one death and a pregnancy loss are tied to an outbreak of listeria food poisoning associated with sliced deli. Listeria is a hardy germ that can be difficult to fully remove once it. 6 hours agoThis is because Listeria can easily spread among food on deli countertops deli slicers surfaces and hands.
7 hours agoListeria is a bacteria that can cause serious and potentially fatal illness for pregnant women people older than 65 and those with vulnerable immune systems according to the. There are two main types of listeriosis. 23 hours ago0120 - Source.
Listeriosis is a series of diseases caused by the bacteria L. California Illinois Maryland Massachusetts New. A deadly outbreak of listeria in six states has been linked to contaminated deli meat and cheese the US Centers for Disease Control and.
For most healthy people it does not cause. Listeria is an organism which can cause serious and sometimes fatal infections in young children frail or elderly people and others with weakened immune. 7 hours agoListeria is a persistent germ that can be hard to get rid of from surfaces and equipment.
States the Centers for Disease Control and Prevention. In most cases listeria infection happens after. Listeria monocytogenes is a bacterium germ that can cause an infection called listeriosis casually referred to just as listeria.
5 hours agoThe warning comes as the CDC investigates a listeria outbreak that sickened 16 people one of whom died in six states. It is a facultative anaerobic bacterium capable of surviving in the presence or absence of. Listeria one of the causes of food poisoning.
Treatment of listeria infection varies depending on the severity of the signs and symptoms. A listeria outbreak linked to deli meats and cheese has resulted in one death and at least 16 infections across 6 states the CDC announced Wednesday. Listeria monocytogenes is an organism which can cause serious and sometimes fatal infections in young children frail or elderly people and others with weakened immune.
This includes the foods we eat. Most people with mild symptoms require no treatment. 3 hours agoA listeria outbreak linked to meats and cheeses sold at deli counters is being investigated by health officials the US Centers for Disease Control and Prevention announced.
Incidence Of Listeria Continues To Decline 2018 03 07 Food Business News
Cdc New Listeria Outbreak Tied To 23 Illnesses 1 Death
Listeria S Most Common Hideouts And How To Minimize Its Risk Of Spreading
A Review Of Listeria In The Uk Food System Food Safety
Questions And Answers Listeria Cdc
192 Listeria Monocytogenes Stock Photos Pictures Royalty Free Images Istock
Figure 3 Scanning Electron Micrograph Of Listeria Monocytogenes Harnessing The Power Of Microbes As Therapeutics Bugs As Drugs Ncbi Bookshelf
Cornell Researchers Discover Five Novel Species To Listeria Genus Food Safety News
Illuminating The Landscape Of Host Pathogen Interactions With The Bacterium Listeria Monocytogenes Pnas
Md Resident Dead 13 Hospitalized After Listeria Outbreak Linked To Deli Meat And Cheese Wjla
Big Olaf Creamery Recalls Ice Cream After Listeria Outbreak
Cdc Ends Listeria Investigation Of Big Olaf Creamery
Listeria Infection In Pregnancy Everyday Health